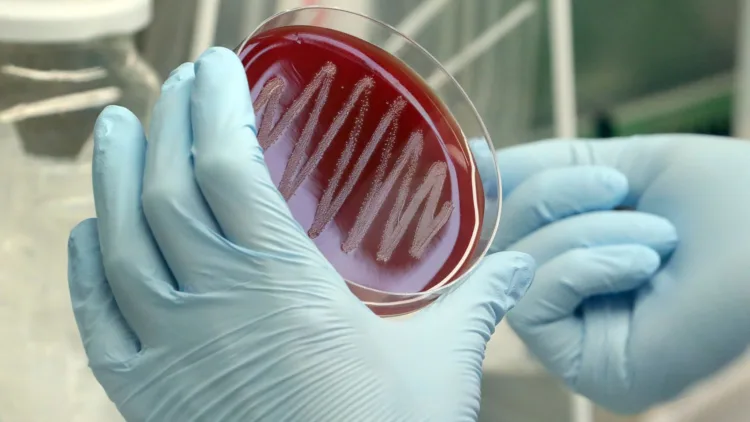
Strep A belirtileri neler, bakteri hangi hastalıklara yol açıyor?

Sağlık uzmanları vakaların önümüzdeki haftalarda artmasını ancak çoğunun hafif atlatılmasını bekliyor.
İngiltere Sağlık Güvenlik Ajansı (UKHSA), Cumartesi günü ülkede Eylül ayından bu yana altı çocuğun Strep A enfeksiyonu nedeniyle öldüğünü söylemişti.
Bu çocuklardan beş tanesi 10 yaşın altında. Galler’de de yedi yaşında bir çocuk yine aynı hastalık nedeniyle hayatını kaybetti.
Pazartesi günü ise biri 12 yaşında Londra’da, diğeri de güneydeki Portsmouth kenti yakınlarında daha genç yaşta bir çocuk olmak üzere iki çocuğun daha yaşamını yitirdiği açıklandı.
İskoçya’da bugüne kadar sekiz ağır Strep A vakası görüldü, ancak buna bağlı ölüm yaşanmadı.
İngiliz sağlık yetkilileri, enfeksiyonla ilgili ailelerin dikkatli olması gerektiğini söyledi.
Pek çok insan bu enfeksiyonla ağır bir hastalık geçirmezken, oldukça bulaşıcı bu bakteriler ciddi hastalıklara ve komplikasyonlara neden olabiliyor.
İngiltere’de 2017-18 yıllarında Strep A enfeksiyonları nedeniyle 10 yaşın altında dört çocuk hayatını kaybetmişti.
Vakalar da geçtiğimiz haftalarda yükseliş gösterdi. Koronavirüs kısıtlamalarının kaldırılmaya başlamasından beri, bu tip enfeksiyonların yayılması da olası.
UKHSA, toplum arasında dolaşan yüksek miktarda bakterinin de artışta önemli bir rol oynadığı görüşünde.
Imperial College London’dan D.r Elizabeth Whittaker, “Pandeminin ilk iki yılında çok az A Grubu Strep gördük. Kısıtlamaların kaldırılmasıyla bakteri 2022’de yeniden dolaşıma girmeye başladı” dedi.
Strep A nedir?
Strep A, boğazda ve deride görülebilecek bir bakteri.
Pek çok insan bakteriyi farkında olmadan zararsız bir şekilde taşıyabilir. Ancak bu hasta olabilecek diğer kişilere bulaştırmasında bir engel değil.
Nasıl yakalanıyor?
İnsanlar bu bakteriyi, yakın temas, öksürük ve hapşırma yoluyla alabiliyor.
Salgınlar okullar ve bakımevlerinde görülebiliyor.
Belirtileri neler?
A Grubu Strep bakterilerinin neden olduğu enfeksiyon normalde boğaz ağrısı ve cilt enfeksiyonları semptomlarıyla hafif atlatılıyor. Antibiyotiklerle de kolayca tedavi edilebiliyor.
Ancak Strep A bakterileri, başka daha ciddi olabilecek bazı hastalıklarla da neden olabilir.
Bunlardan biri de çoğunlukla çocukları etkileyen kızıl hastalığı (scarlet). Bu hastalık için de antibiyotiğe ihtiyaç duyuluyor.
Kızıl hastalığı nedir?
Halk sağlığı yetkililerine bildirilmesi gereken bulaşıcı bir hastalık olan kızıl hastalığı, bu sayede hızlı bir şekilde tedavi edilebilir ve salgınlar kontrol altına alınabilir.
Döküntü ile birlikte ateş, boğaz ağrısı ve boyun bezlerinin şişmesi gibi grip benzeri semptomlara neden olur.
Kızarıklığın daha koyu ciltlerde tespiti daha zordur. Ancak pütürlü bir yüzey hissi verir.
Kızıl hastalığı geçiren bazı kişilerde dil, çilek dili olarak adlandırılan bir görünüme sahip olabilir. Dil, beyaz bir iltihapla kaplanır. İltihabın ortadan kalkmasıyla da dil kırmızı üzeri noktalı bir görünüm elde eder.
Strep A tehlikeli mi?
Nadir de olsa Strep A, iGAS olarak bilinen ve A grubu streptokoksik enfeksiyona yol açabilir.
Bu ölümcül bir sonuç doğurabilir.
Bu hastalık, bakterilerin bağışıklık sistemine geçmesiyle yaşanır. Eğer zaten hastaysanız ya da kanser gibi hastalıkların tedavisi altındaysanız, bu sizin bağışıklık sisteminizi etkileyebilir.
Hastalığın 38 derecenin üzerinde yüksek ateş ve şiddetli kas ağrıları gibi belirtileri olur.
Acil, erken tıbbi yardım çok önemlidir.
UKHSA, yukarıdaki belirtilerle ek olarak açıklanamayan kusma ve ishal şikayetleri de varsa insanların sağlık birimlerine başvurmaları yönünde uyarılarda bulundu.
Çocuğunuz Strep A’nın neden olabileceği bir semptoma sahipse doktorunuzla konuşmalısınız.
Strep A’ya sahip birisiyle temas halinde olup olmadığınız belirtmeniz de oldukça önemli.
Aşısı var mı?
Hayır.
Strep A, antibiyotiklerle tedavi ediliyor. (BBC Türkçe)